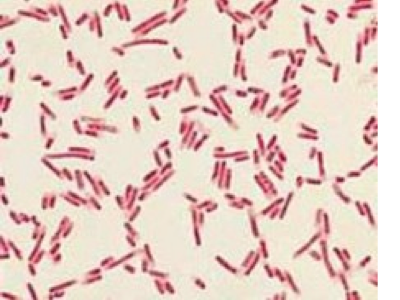

Sign up for FlowVella
Sign up with FacebookAlready have an account? Sign in now
By registering you are agreeing to our
Terms of Service
Loading Flow

Gram negative bacteria do not retain violent stain.
E. Coil is a gram negative.
Can be harmful and cause infection.
Prokaryotic Cells